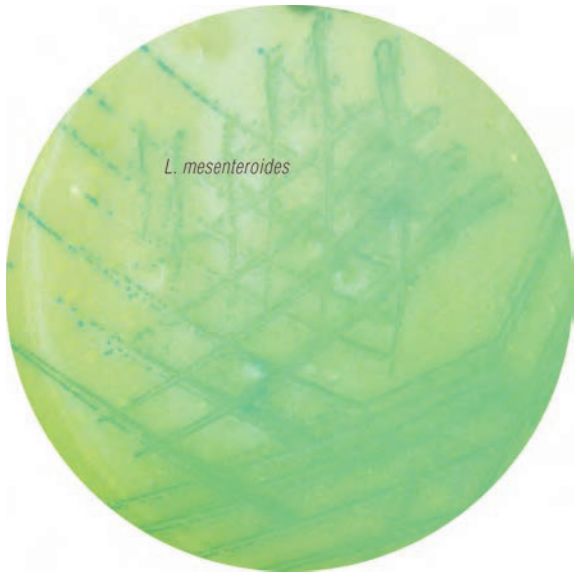
『明串珠菌』培养——食品香气四溢的秘密！

北京缔一生物科技有限公司品牌商
9 年
手机商铺
- NaN
- 0
- 0
- 1
- 0
推荐产品
公司新闻/正文
『明串珠菌』培养——食品香气四溢的秘密!
318 人阅读发布时间:2019-10-24 11:30
每当走进面包店或蛋糕房,人们总能闻到一股浓浓的奶油香味。
散发香味的食品还有,酸奶和干酪的香气、葡萄酒的酒香以及果汁、香肠的香气等。这些香味会刺激人们的食欲,从而产生品尝购买的愿望。
那么,这些香味是哪里来的呢?
这样工艺又是需要怎样的操作呢?

『明串珠菌』是产生食品香味的重要原因
『明串珠菌』是发酵剂中的重要微生物,它在乳制品等食品工业中被广泛应用,是食品产生香味的重要原因。
『明串珠菌』是菌属名,属于乳酸菌,人们把它又细分为肠膜明串珠菌、柠檬明串珠菌等13个种。其中,『肠膜明串珠菌』又分为三个亚种。『明串珠菌』最大特点是分解食物中的柠檬酸,产生双yi酰和芳香族物质,从而有助于食品香气和风味的形成。
因此在食品工业中,例如生产发酵奶油的时候,会有意地培养明串珠菌,再人为添加一点柠檬酸,经过适当的培养和精细的工艺过程,香味就可扑鼻而来了。
『明串珠菌』的工艺应用
『明串珠菌』常被用于黄油、发酵乳以及干酪的发酵生产,它也是葡萄酒发酵和香肠生产的主要菌种。在实际生产中,需投入活的『明串珠菌』(必要时使用发酵剂),通过『明串珠菌』不同浓度的控制,可以保证食品的不同风味。
因此,通过『明串珠菌』的培养,以及数量的准确检测,是保证食品风味的重要手段。
『明串珠菌』培养筛选的传统方法:
1.将菌液接种到MRS选择性培养基平板中,
2.涂布均匀,
3.在30℃培养24h~36h,
4.待菌落长出后,挑取典型菌落,
5.在含有万古霉素的MRS固体培养基上划线,
6.30℃培养24h~36h,
7.有菌落生长后再进行鉴定。
传统方法,操作繁琐,特异性不高,
还耗费大量的时间和人力。
随着食品风味的工艺要求,以及食品生产和质控的快速高效的要求,食品厂迫切需要一种新型高效的方法。
『明串珠菌』培养筛选,快速高效新方法
近年来,国际上已有:APHA(美国公共卫生协会),“ISO17792”条例规范等文件,对『明串珠菌』一类的乳酸菌培养提出了『Nickels and Leesment培养基』的新型方法,通过【酸菌显色培养基】的直接显色培养,可快速准确地用于『明串珠菌』的鉴别和计数。同时,还可鉴别其他参与香味形成的乳酸乳球菌。
目前,国际上知名乳品或食品厂,大多选用的世界著名品牌Himedia公司研发生产的【乳酸菌显色培养基】(货号:MV1712),此款显色培养基不但能完美满足快速高效地鉴别计数的要求,同时,更是全球领先的『非动物源性』配方。『非动物源性』培养基在食品制药领域,具有更安全,更符合食药监采购原则等如下优势:
1. 避免动物源成分带来的BSE/TSE(疯牛病)传播风险;
2. 批间差异更小,结果稳定;
3. 该培养基在生产过程中CO2排放更少,消耗地球资源更少;
4. 使食品生产的工艺流程申报更简便。
只需将样品液接种到【乳酸菌显色培养基】中,25-30°C培养48~72h,直接观察即可。结果:『明串珠菌』为蓝色菌落,乳酸乳球菌为白色菌落,其中乳酸乳球菌双yi酰亚种有光晕,而乳酸乳球菌乳酸亚种和乳脂亚种均没有光晕。如要进行『明串珠菌』计数,可添加万古霉素,抑制各种乳酸乳球菌的生长(下图)。
【乳酸菌显色培养基】(货号:MV1712)
配制及操作步骤:
1. 取66.0g【乳酸菌显色培养基】(货号:MV1712)干粉溶于1L蒸馏水。加热煮沸使培养基全部溶解。15磅121℃高压灭菌15分钟;
( 如需做『明串珠菌』的计数试验,则需第2,3步。否则,可直接进入第4步)
2.取2管添加剂万古霉素(货号FD245),每管加5ml无菌蒸馏水溶解;
3. 待显色培养基冷却至45-50℃时,加入2管溶解好的万古霉素添加剂,混匀。
4. 每个90mm平皿倾注12-15ml配制好的【乳酸菌显色培养基】;
5. 倾注后,立即加入接种液,晃动平皿,使接种液与培养基混匀,并等待培养基凝固;
6.  25-30°C培养48-72h,观察结果并计数;
7. 挑取菌落进行革兰氏染色,确证它们为革兰氏阳性、触酶阴性的球菌或双球菌。
关于以上培养基的订货信息:
产品信息

品名:乳酸菌显色培养基
英文名:HiCrome Nickels and Leesment HiVeg Medium
货号:MV1712
储存:2-8°C
规格:100G/瓶 、500G/瓶
生产商: HiMedia  Laboratories
生产地:印度
品名:万古霉素  (显色培养基专用添加剂,可选购)
英文名:HiCrome Nickels & Leesment Selective Supplement
货号:FD245-5VL
规格:5 管/包
储存:2-8°C
HiMedia生产厂家介绍:
HiMedia  Laboratories公司是世界著名的培养基生产厂家,总部位于印度,有近50年的生产研发经验。HiMedia公司的显色培养基种类齐全、性价比高,具有WHO-GMP认证、ISO9001,ISO13485认证,CE和FDA注册登记。其产品已行销全球140多个国家。
北京缔一生物作为HiMedia公司的总代理,在2015年将HiMedia产品正式引入中国。北京缔一生物被中国生物界誉为值得“持续信赖的供货商”,在微生物检测领域有着专业的技术背景,为中国的食品厂、乳制品厂、药厂、疫苗厂等,提供专业的技术支持和产品。







